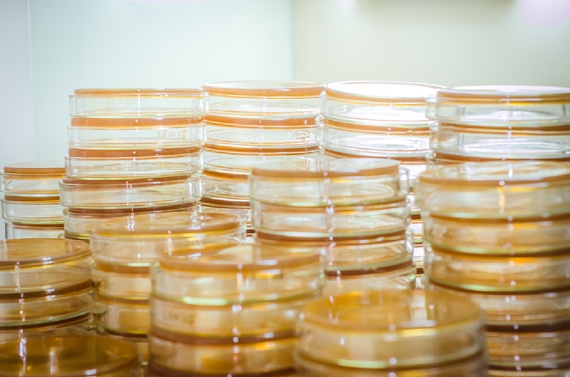
lead (1)

We appreciate the increased interest, across all the media we track, to the cultural and environmental aspects of beer production. Thanks to the Atlantic‘s intrepid investigators for this one:
In late November of 2009, the town of Cockermouth, in the Lake District of England, had a flood. Heavy rains—16 inches in 24 hours—led the rivers Cocker and Derwent to overflow their stone barriers; the buildings of the medieval town, as a result, ended up submerged in 10 feet of water. Among those buildings was Jennings Brewery, one of the few establishments in the world that brews real ale—a beer, rich and dark and featuring a texture that connoisseurs might call “chewy.” Real ale is, to the extent that beers resemble animals, endangered. This is partly because it requires a very particular type of yeast in its brewing: a yeast that, during fermentation, sits on top of the wort, the sugary liquid extracted from the mashing process, rather than sinking to the bottom.
“The yeast,” Adam Rogers writes in his new book Proof: The Science of Booze, “is one of the main things that makes ale special.” And after the Cockermouth flood, Jennings’ strain of yeast “was gone. Drowned.”
This led Rebecca Adams, head of the lab at Jennings—because what is beer-brewing, ultimately, if not lab work—to a four-story building in Norwich, nearly 300 miles southwest of Cockermouth. The building houses Britain’s National Collection of Yeast Cultures, which is, as its name suggests, a repository of the microbes that help humans produce booze. The repository is, as the NCYC describes itself, “the UK’s premier collection of yeast cultures”: It holds more than 4,000 strains of the stuff, 800 of them brewing yeasts, that have been collected over the past 65 years. The yeast in the archive isn’t simply used for beer-brewing and booze-distilling; it also has applications in medicine (cancer research, for example) and industry.
For Jennings, however, the NCYC—a living database, literally—was a very particular kind of insurance policy. Its lab had deposited a sample of the Jennings brewing yeast, the key component in its signature ale recipe, with the Center. Which meant that, even after the flood, it could keep brewing. (It borrowed other brewers’ equipment while it rebuilt its own facilities.)
The Center preserves its samples of yeast in a form called “slope,” suspended in agar in glass vials and then frozen. It also makes backups of the brewers’ backups, in the form of freeze-dried yeast powder, sealed inside glass ampules and stored inside cabinets—they resemble filing cabinets, Rogers notes—in a large, refrigerated room. “Their tops have the pulled-taffy look of glass that’s been melted over a Bunsen burner,” he writes. “Inside each is a bit of cotton and a puff of white dust. That’s the yeast.”
The yeast is, in its way, living history…
Read the whole post here.
Pingback: Traditional Soaking, London Edition | Raxa Collective